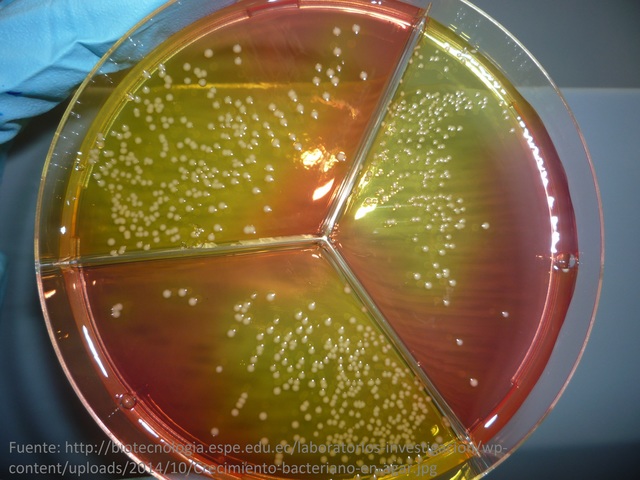
Auge de ciencia en Ingenieria Quimica VII

-
Henry Armstrong integro un plan de estudio el cual incluia materias como Quimica, Matematicas, Fisica e Ingenieria Mecanica, el cual no tuvo mucho exito por ser una mezcla "muy rara".
-
-
Georges Edwards Davis, quien era consultor e inspector de la industria de los álcalis, empezo a ver los procesos quimicos como una serie operaciones sencillas, considerando los proces de manufactura quimica como una consecuencia de estas.
-
Se impartio en el Michigan Institute of Technology.
-
Se dio a principio de la decada de 1900
-
En este año Edward Davis publico el primer curso de Ingenieria Quimica, titulado manual de Ingenieria Quimica.
-
Los balances de materia y energia se empezaron a emplear y a estudiar.
-
Gracias a que ya existian Ingenieros Quimicos con necesidad de encontrar datos como parametros fisicoquimicos, constantes fisicas etc., se pudo compilar un libro con bastante informacion util para la rama.
-
El primero en introducir la Ingenieria Quimica en Mexico fue Estanislao Ramirez Ruiz en la escuela de Tacuba en la Facultad de Quimica y Farmacia y Escuela Practica de Industrias Quimicas.
-
Decada del auge de termodinamica en Ingenieria Quimica.
-
En este año se publico la primera edicion del que se considera hasta la fecha el mejor amigo del Ingeniero Quimico llamado Chemical Engineers Handbook de John H. Perry.
-
Gracias a los esfuerzos de varios Ingenieros Quimicos se pudo hacer una compilacion de datos para que creara el libro de Chemical Engineering Thermodynamics por H.C. Webey.
-
Se estudio mas a fondo los efectos cataliticos en las reacciones con el fin de obtener productos quimicos de una manera mas eficiente.
-
Optimizar costos en la industria empezaba a tener auge y se demostraba en textos como Chemical Engineering Economics que fue de los primeros en el tema.
-
La decada de la optimizacion de procesos y costos.
-
Gracias a que ya se tenia mas conocimiento en areas claves de la Ingenieria Quimica despues de la segunda guerra mundial, se empezaron a enfocar mas en diseño de plantas optimas. El libro de Chemical Engineering Plant Design ejemplifica perfectamente esta era.
-
Se publico un libro que revoluciono las operaciones unitarias gracias a que a partir de este el enfoque es mas matematico y fisico y esto gracias a los esfuerzos de R.B. Bird, W.E. Stewart y E.N. Lightfoot.
-
Las tecnicas computacionales aparecieron gracias a la complejidad de los problemas matematicos.
-
Por la creacion de los fenomenos de transporte y su complejidad de resolucion de problemas surgieron tambien las resolucion de problemas con apoyo de computadoras y en textos como Process modeling, simulation and control for chemical engineers de William L. Luyben se demuestran los procedimientos.
-
La ingenieria ambiental entro en rigor en los años ochenta gracias al descuido que se tenia antes al medio por los procesos industriales.
-
La biotecnologia aparecio despues de la ingenieria ambiental ya que estan practicamente ligadas.
-
Gracias a que actualmente se logran avances tecnologicos muy rapidamente, la Ingenieria Quimica contemporanea tiene areas como la nanotecnologia ya que es la tecnologia que se requiere en el presente y se cree que sera la del futuro.
Looking for a timeline maker?
Create timelines for projects, roadmaps, history, lessons, legal cases, and stories with Timetoast. Timetoast is a timeline maker for work, school, research, and stories.